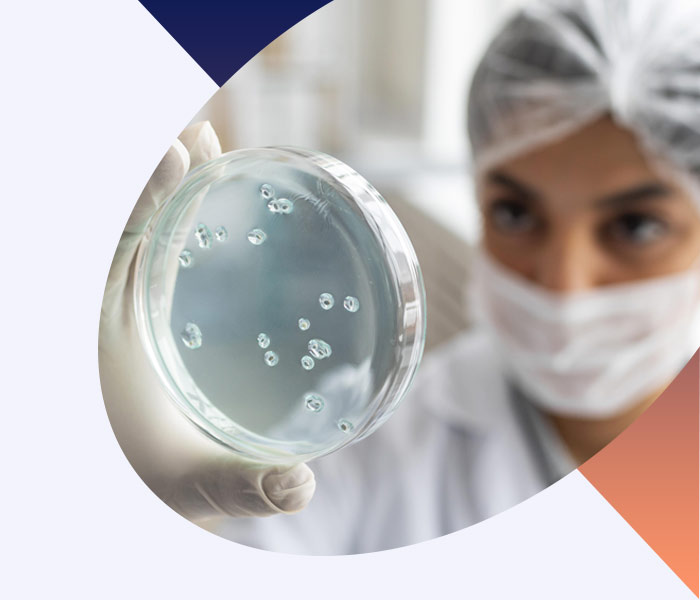
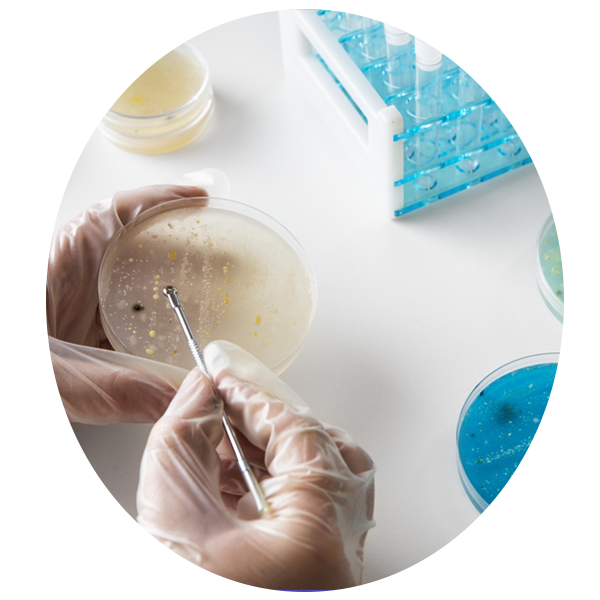

The best way to boost your chances of success is to focus on the factors you can control. By making mindful choices around lifestyle, nutrition, and physical activity, you can help your body work with you—not against you—on your fertility journey.
Here are some key areas to prioritize:
Preconception Health – Making healthy lifestyle changes now can have a lasting impact. Start with our free 90-Day Preconception Checklist to learn what steps you can take today to support your future success.
Fertility Testing – While it’s tempting to jump right into treatment, completing your diagnostic cycle first gives your doctor and Care Team the information they need to create the most effective, personalized plan for you.
Holistic Fertility Support – Research shows that adding supportive therapies—like counseling, acupuncture, nutritional guidance, and support groups—can enhance your overall well-being and may even improve outcomes. At Illume Fertility, every patient has access to our Integrated Fertility & Wellness (IFW) program, designed to care for both mind and body.
Preimplantation Genetic Testing (PGT) – Especially beneficial for older patients, PGT helps evaluate embryo quality and identify chromosomal or structural abnormalities that could affect implantation success or a baby’s health.